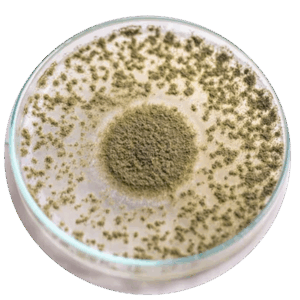

Micotoxinas
MICOTOXÍNAS
Las micotoxinas son metabolitos fúngicos que tienen un impacto negativo en la salud y productividad animal. El desarrollo del hongo y la producción de micotoxinas depende de una combinación de factores que involucran; la temperatura, la humedad, el oxígeno disponible y el tipo de sustrato, entre otros.
Por lo anterior resulta importante monitorear la ocurrencia y concentración de estos compuestos, para poder implementar programas de manipulación de los alimentos que permitan aminorar el problema de micotoxicosis y sus efectos sobre la salud animal.

Laboratorio
Asesoría para toma de muestras.
- Lun-Vier: 8:00 am - 4:00 pm
- 442 227 44 56
- 442 721 00 45
- recepcion.laboratorio@gaqsa.com
Análisis de laboratorio diseñadas para detectar y cuantificar la presencia de micotoxinas en alimentos, forrajes y materias primas.
TIEMPO DE ENTREGA 2 días hábiles | TÉCNICA Elisa
| ANÁLISIS | PAQUETE | PAQUETE | TIPO DE MUESTRA |
| RUMIANTES | CERDOS | Maíz, glúten de maíz, sorgo, trigo, soya, arroz, cebada, DDGs. | |
| AFLATOXINAS |
* |
Maíz, glúten de maíz, sorgo, trigo, soya, arroz, cebada, DDGs. | |
| ZEARALENONA | * | Maíz, glúten de maíz, sorgo, trigo, soya, arroz, cebada, DDGs. | |
| DEOXINIVALENOL | * | * | Maíz, glúten de maíz, sorgo, trigo, soya, arroz, cebada, DDGs. |
| TOXINA T-2 | * | * | Maíz, glúten de maíz, sorgo, trigo, soya, arroz, cebada, DDGs. |
| OCRATOXINA | * | Maíz, glúten de maíz, sorgo, trigo, soya, arroz, cebada, DDGs. | |
| FUMONISINA | Maíz, glúten de maíz, sorgo, trigo, soya, arroz, cebada, DDGs. |




Análisis de micotoxinas basado en el método ELISA:
AFLATOXINAS
-
Tienen actividad cancerígena, teratogénica y mutagénica. Los principales órganos afectados son el hígado, el riñón y el cerebro. Son inmunosupresivas. La Aflatoxina M1 es la más toxica de todas las Aflatoxinas y se le encuentra en la leche, por lo que puede afectar la salud; la Aflatoxina M1 se obtiene de biotransformación de la alfatoxina B1 presente en el alimento de la vaca. Los animales más sensibles son: aves, cerdos, conejos y rumiantes.
DOXINIVALEINOL
-
Reduce notablemente el consumo de alimento, causa vómito, es inmunosupresora y puede causar problemas en riñón. Los animales más sensibles son: cerdos, rumiantes y aves.
ZEARALENONA
-
Afecta significativamente el ciclo reproductivo de los animales, causando problemas estrogénicos y de abortos. Los animales más sensibles son: cerdos, caballos y rumiantes.
OCRATOXINA
-
Causan daño en riñón e hígado, y son inmunosupresoras. Los animales más sensibles son: cerdos y aves, los rumiantes destoxifican a nivel ruminal esta micotoxina.
TOXINA T-2
-
Produce necrosis de las mucosas del tracto gastrointestinal, degeneración de la médula ósea y una significativa inhibición del sistema inmune. Los animales más sensibles son: aves, cerdos, rumiantes, caballos y conejos.
FUMONISIMA
-
Son neurotóxicas (causan leucoencefalomelacia), nefrotóxicas, hepatotóxicas, producen lesiones cardiacas, edema pulmonar y cerebral. Los animales más sensibles son: caballos, cerdos, ovejas, carneros y mandrile














